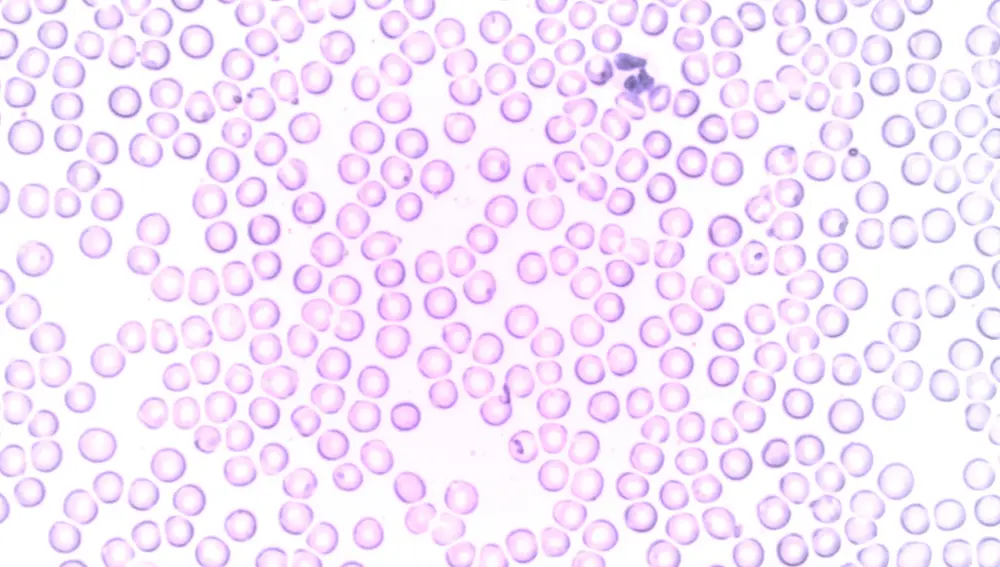
Glóbulos blancos Glóbulos blancos

PROPIEDADES ANTICANCERÍGENAS
Un reciente descubrimiento revela que una infección grave por COVID-19 puede reducir el tamaño de los tumores
Este hallazgo abre nuevas posibilidades para el tratamiento del cáncer y arroja luz sobre las complejas interacciones entre el sistema inmunológico y las células cancerosas.

Publicidad
Con todo lo malo que nos ha dado la COVID-19, lo de hoy son buenas noticias. Y es que, un nuevo estudio ha revelado un beneficio potencial inesperado de la infección grave por COVID: puede ayudar a reducir el cáncer.
Este sorprendente hallazgo, basado en investigaciones realizadas en ratones, abre nuevas posibilidades para el tratamiento del cáncer y arroja luz sobre las complejas interacciones entre el sistema inmunológico y las células cancerosas. Pero ojo, esto no significa que las personas deban intentar contraer COVID.
El estudio se centró en un tipo de glóbulo blanco llamado monocitos. Estas células inmunitarias desempeñan un papel crucial en la defensa del organismo contra infecciones y otras amenazas.
Sin embargo, en pacientes con cáncer, los monocitos a veces pueden ser secuestrados por células tumorales y transformados en células amigables con el cáncer que protegen al tumor del sistema inmunológico.
Lo que descubrieron los investigadores fue que la infección grave por COVID hace que el cuerpo produzca un tipo especial de monocitos con propiedades anticancerígenas únicas. Estos monocitos "inducidos" están específicamente entrenados para atacar al virus, pero también conservan la capacidad de combatir las células cancerosas.
Para comprobar si estos monocitos podrían inspirar un tratamiento contra el cáncer, los autores del estudio utilizaron roedores con distintos tipos de tumores avanzados en fase IV. Había ratones con melanoma y otros con cáncer de pulmón, mama o colon.
Todos ellos recibieron un medicamento que imita la respuesta inmunitaria de una infección grave por el virus de la COVID-19. Esta respuesta contenía también esos monocitos que no se doblegan ante los tumores.
El resultado fue que las células tumorales no pudieron secuestrarlos. Pero además, estos monocitos fueron capaces de migrar hacia el tumor, algo que pocas células inmunitarias pueden hacer. Una vez allí, marcaron las células para su destrucción y reclutaron a las natural killer, otras células inmunitarias que se encargan de asesinar a las amenazas.
Todos los tumores de los ratones se redujeron gracias a los monocitos de la COVID-19. Ahora, solo queda saber si este mecanismo podría convertirse en un tratamiento contra el cáncer en humanos.
Publicidad